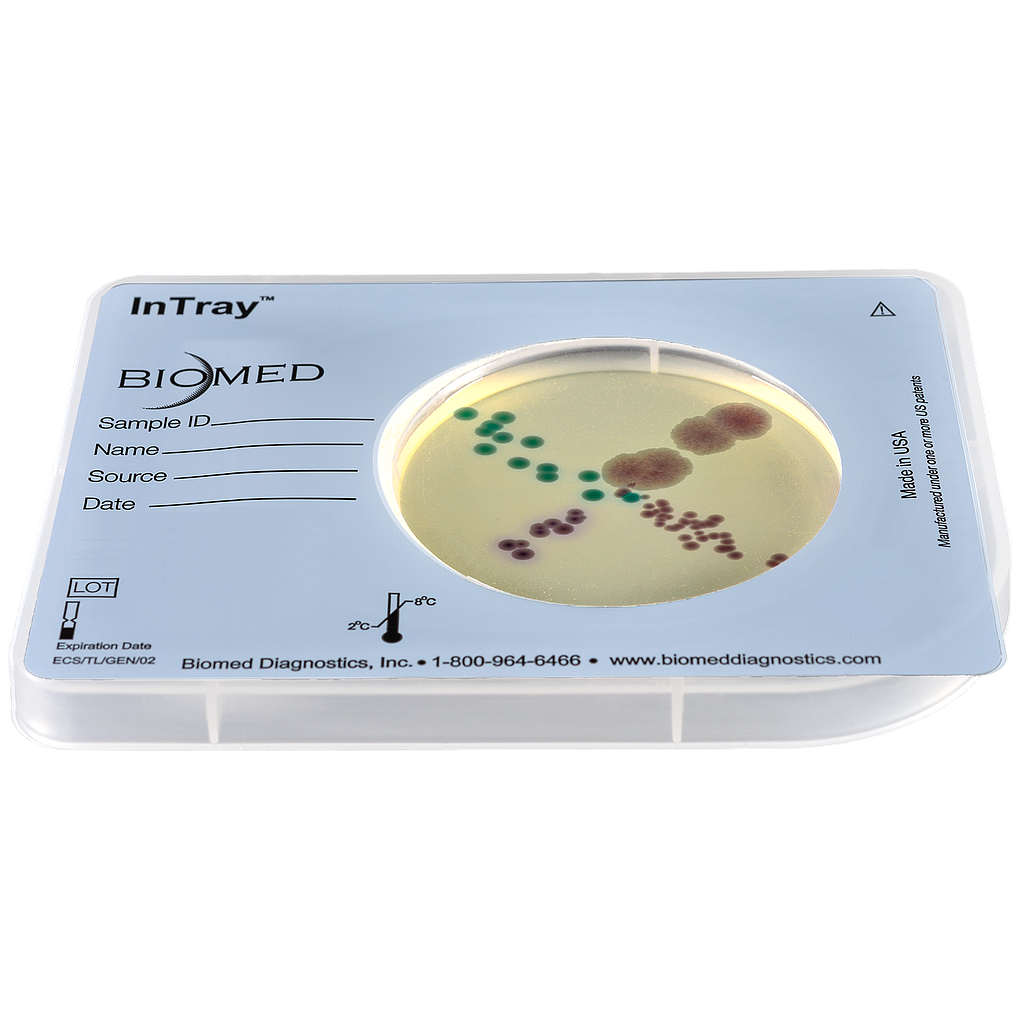
InTray COLOREX™ Yeast 20pk

InTray COLOREX™ Yeast 20pk
Colorex Yeast is a specialized device that allows for simultaneous growth, detection and chromogenic differentiation of Candida species, as well as Malassezia pachydermatis. Samples are traditionally taken from skin, sputum, urine, or vaginal swabs.
Chromogenic differentiation of:
Candida albicans
Appears green in media well
Duplicate
Appears metallic blue in media well
Candida krusei
Appears fuzzy and pink in media well.
Candida glabrata
Appears white to mauve in media well
Quick Facts
The important stuff.
Time to result
48 hours, incubate at 37°C.
Storage
Extended 12 month shelf life (2-8°C) from the date of manufacture
Can tolerate extended periods at controlled room temp (≤ 25˚C), with no loss in performance.
Specimen
Skin | Sputum | Urine | Genito-urethral swabs